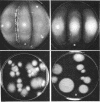

Abstract
Mutants of Aspergillus fennelliae (Neosartorya fennelliae) resistant to relatively high levels of amphotericin B and low levels of nystatin were obtained by successive transfers of wild type in the presence of increasing concentrations of the polyenes. The resistance of the mutants to the polyenes was accompanied by both qualitative and quantitative changes in the sterol composition of the cells. Those resistant to amphotericin B (AF5-AB1 and p-AB1) lacked ergosterol, the major sterol of the wild type, but contained a new sterol clearly distinguished by the pattern of ultraviolet spectrophotometry and thin-layer chromatography. The mutants resistant to nystatin, however, contained both ergosterol and a new sterol, but the former was produced in a much reduced amount, as compared with the wild type. Genetic analysis indicated that the lack of ergosterol is closely associated with a reduced growth rate, poor asexual reproduction, and the loss of sexual reproduction. Growth studies revealed that the addition of ergosterol to the media did not affect the growth pattern of the mutants. Mutants resistant to amphotericin B showed an increased minimal inhibitory concentration for nystatin, pimaricin, and filipin. Mutants resistant to nystatin, however, conferred increased minimal inhibitory concentration for pimaricin and filipin but not for amphotericin B.
Full text
PDF











Images in this article
Selected References
These references are in PubMed. This may not be the complete list of references from this article.
- Ahmed K. A., Woods R. A. A genetic analysis of resistance to nystatin in Saccharomyces cerevisiae. Genet Res. 1967 Apr;9(2):179–193. doi: 10.1017/s0016672300010478. [DOI] [PubMed] [Google Scholar]
- Bard M. Biochemical and genetic aspects of nystatin resistance in saccharomyces cerevisiae. J Bacteriol. 1972 Sep;111(3):649–657. doi: 10.1128/jb.111.3.649-657.1972. [DOI] [PMC free article] [PubMed] [Google Scholar]
- Bodenhoff J. Development of strains of Cryptococcus neoformans resistant to nystatin, amphotericin B, trichomycin and polymyxin B. Acta Pathol Microbiol Scand. 1968;73(4):572–582. doi: 10.1111/j.1699-0463.1968.tb03215.x. [DOI] [PubMed] [Google Scholar]
- Bodenhoff J. Development of strains of genus Candida and genus Torulopsis resistant to antimycotics. Acta Pathol Microbiol Scand. 1969;75(4):622–630. [PubMed] [Google Scholar]
- Brandsberg J. W., French M. E. In vitro susceptibility of isolates of Aspergillus fumigatus and Sporothrix schenckii to amphotericin B. Antimicrob Agents Chemother. 1972 Nov;2(5):402–404. doi: 10.1128/aac.2.5.402. [DOI] [PMC free article] [PubMed] [Google Scholar]
- Bulder C. J. Anaerobic growth, ergosterol content and sensitivity to a polyene antibiotic, of the yeast Schizosaccharomyces japonicus. Antonie Van Leeuwenhoek. 1971;37(3):353–358. doi: 10.1007/BF02218505. [DOI] [PubMed] [Google Scholar]
- Butler W. T., Cotlove E. Increased permeability of human erythrocytes induced by amphotericin B. J Infect Dis. 1971 Apr;123(4):341–350. doi: 10.1093/infdis/123.4.341. [DOI] [PubMed] [Google Scholar]
- CIRILLO V. P., HARSCH M., LAMPEN J. O. ACTION OF THE POLYENE ANTIBIOTICS FILIPIN, NYSTATIN AND N-ACETYLCANDIDIN ON THE YEAST CELL MEMBRANE. J Gen Microbiol. 1964 May;35:249–259. doi: 10.1099/00221287-35-2-249. [DOI] [PubMed] [Google Scholar]
- Clayton Y. M. Antifungal drugs for oculomycosis. II. Sensitivity of certain ocular fungi to antifungal drugs. Trans Ophthalmol Soc U K. 1970;89:837–844. [PubMed] [Google Scholar]
- DEMEL R. A., VAN DEENENL PENETRATION OF LIPID MONOLAYERS BY POLYENE ANTIBIOTICS. CORRELATION WITH SELECTIVE TOXICITY AND MODE OF ACTION. J Biol Chem. 1965 Jun;240:2749–2753. [PubMed] [Google Scholar]
- FEINGOLD D. S. THE ACTION OF AMPHOTERICIN B ON MYCOPLASMA LAIDLAWII. Biochem Biophys Res Commun. 1965 Apr 9;19:261–267. doi: 10.1016/0006-291x(65)90515-2. [DOI] [PubMed] [Google Scholar]
- GHOSH B. K., CHATTERJEE A. N. Leishmanicidal activity of nystatin, a polyene antifungal antibiotic. I. The probable mechanism of action of nystatin on Leishmania donovani. Antibiot Chemother (Northfield) 1962 Mar;12:204–206. [PubMed] [Google Scholar]
- Gordon H. W., Schaffner C. P. The effect of polyene macrolides on the prostate gland and canine prostatic hyperplasia. Proc Natl Acad Sci U S A. 1968 Aug;60(4):1201–1208. doi: 10.1073/pnas.60.4.1201. [DOI] [PMC free article] [PubMed] [Google Scholar]
- Grindle M. Sterol mutants of Neurospora crassa: their isolation, growth characteristics and resistance to polyene antibiotics. Mol Gen Genet. 1973 Feb 2;120(3):283–290. doi: 10.1007/BF00267158. [DOI] [PubMed] [Google Scholar]
- Hamilton-Miller J. M. Chemistry and biology of the polyene macrolide antibiotics. Bacteriol Rev. 1973 Jun;37(2):166–196. [PMC free article] [PubMed] [Google Scholar]
- Hamilton-Miller J. M. Physiological properties of mutagen-induced variants of Candida albicans resistant to polyene antibiotics. J Med Microbiol. 1972 Nov;5(4):425–440. doi: 10.1099/00222615-5-4-425. [DOI] [PubMed] [Google Scholar]
- Hamilton-Miller J. M. Sterols from polyene-resistant mutants of Candida albicans. J Gen Microbiol. 1972 Nov;73(1):201–203. doi: 10.1099/00221287-73-1-201. [DOI] [PubMed] [Google Scholar]
- KINSKY S. C., AVRUCH J., PERMUTT M., ROGERS H. B. The lytic effect of polyene antifungal antibiotics on mammalian erythrocytes. Biochem Biophys Res Commun. 1962 Dec 19;9:503–507. doi: 10.1016/0006-291x(62)90116-x. [DOI] [PubMed] [Google Scholar]
- KINSKY S. C. Alterations in the permeability of Neurospora crassa due to polyene antibiotics. J Bacteriol. 1961 Dec;82:889–897. doi: 10.1128/jb.82.6.889-897.1961. [DOI] [PMC free article] [PubMed] [Google Scholar]
- KINSKY S. C. Nystatin binding by protoplasts and a particulate fraction of Neurospora crassa, and a basis for the selective toxicity of polyene antifungal antibiotics. Proc Natl Acad Sci U S A. 1962 Jun 15;48:1049–1056. doi: 10.1073/pnas.48.6.1049. [DOI] [PMC free article] [PubMed] [Google Scholar]
- Kinsky S. C. Antibiotic interaction with model membranes. Annu Rev Pharmacol. 1970;10:119–142. doi: 10.1146/annurev.pa.10.040170.001003. [DOI] [PubMed] [Google Scholar]
- LAMPEN J. O., ARNOW P. M., BOROWSKA Z., LASKIN A. I. Location and role of sterol at nystatin-binding sites. J Bacteriol. 1962 Dec;84:1152–1160. doi: 10.1128/jb.84.6.1152-1160.1962. [DOI] [PMC free article] [PubMed] [Google Scholar]
- LAMPEN J. O., ARNOW P. M., SAFFERMAN R. S. Mechanism of protection by sterols against polyene antibiotics. J Bacteriol. 1960 Aug;80:200–206. doi: 10.1128/jb.80.2.200-206.1960. [DOI] [PMC free article] [PubMed] [Google Scholar]
- LAMPEN J. O., ARNOW P. Inhibition of algae by nystatin. J Bacteriol. 1961 Aug;82:247–251. doi: 10.1128/jb.82.2.247-251.1961. [DOI] [PMC free article] [PubMed] [Google Scholar]
- Lampen J. O. Amphotericin B and other polyenic antifungal antibiotics. Am J Clin Pathol. 1969 Aug;52(2):138–146. doi: 10.1093/ajcp/52.2.138. [DOI] [PubMed] [Google Scholar]
- Molzahn S. W., Woods R. A. Polyene resistance and the isolation of sterol mutants in Saccharomyces cerevisiae. J Gen Microbiol. 1972 Sep;72(2):339–348. doi: 10.1099/00221287-72-2-339. [DOI] [PubMed] [Google Scholar]
- Monner D. A., Parks L. W. A method for extraction of sterols from enzymically active cell-free preparations. Anal Biochem. 1968 Oct 24;25(1):61–69. doi: 10.1016/0003-2697(68)90081-x. [DOI] [PubMed] [Google Scholar]
- Norman A. W., Demel R. A., de Kruyff B., Geurts van Kessel W. S., van Deenen L. L. Studies on the biological properties of polyene antibiotics: comparison of other polyenes with filipin in their ability to interact specifically with sterol. Biochim Biophys Acta. 1972 Dec 1;290(1):1–14. doi: 10.1016/0005-2736(72)90046-6. [DOI] [PubMed] [Google Scholar]
- Norman A. W., Demel R. A., de Kruyff B., van Deenen L. L. Studies on the biological properties of polyene antibiotics. Evidence for the direct interaction of filipin with cholesterol. J Biol Chem. 1972 Mar 25;247(6):1918–1929. [PubMed] [Google Scholar]
- Parks L. W., Bond F. T., Thompson E. D., Starr P. R. 8(9),22 -Ergostadiene-3 -ol, an ergosterol precursor accumulated in wild-type and mutants of yeast. J Lipid Res. 1972 May;13(3):311–316. [PubMed] [Google Scholar]
- Patel P. V., Johnston J. R. Dominant mutation for nystatin resistance in yeast. Appl Microbiol. 1968 Jan;16(1):164–165. doi: 10.1128/am.16.1.164-165.1968. [DOI] [PMC free article] [PubMed] [Google Scholar]
- Rottem S. Differentiation of sterol-requiring from sterol-nonrequiring mycoplasmas by amphotericin B. Appl Microbiol. 1972 Mar;23(3):659–660. doi: 10.1128/am.23.3.659-660.1972. [DOI] [PMC free article] [PubMed] [Google Scholar]
- Rottem S., Pfendt E. A., Hayflick L. Sterol requirements of T-strain mycoplasmas. J Bacteriol. 1971 Jan;105(1):323–330. doi: 10.1128/jb.105.1.323-330.1971. [DOI] [PMC free article] [PubMed] [Google Scholar]
- SUTTON D. D., ARNOW P. M., LAMPEN J. O. Effect of high concentrations of nystatin upon glycolysis and cellular permeability in yeast. Proc Soc Exp Biol Med. 1961 Oct;108:170–175. doi: 10.3181/00379727-108-26882. [DOI] [PubMed] [Google Scholar]
- Schaffner C. P., Gordon H. W. The hypocholesterolemic activity of orally administered polyene macrolides. Proc Natl Acad Sci U S A. 1968 Sep;61(1):36–41. doi: 10.1073/pnas.61.1.36. [DOI] [PMC free article] [PubMed] [Google Scholar]
- Schroeder F., Holland J. F., Bieber L. L. Fluorometric investigations of the interaction of polyene antibiotics with sterols. Biochemistry. 1972 Aug 1;11(16):3105–3111. doi: 10.1021/bi00766a026. [DOI] [PubMed] [Google Scholar]
- Verkleij A. J., de Kruijff B., Gerritsen W. F., Demel R. A., van Deenen L. L., Ververgaert P. H. Freeze-etch electron microscopy of erythrocytes, Acholeplasma laidlawii cells and liposomal membranes after the action of filipin and amphotericin B. Biochim Biophys Acta. 1973 Jan 26;291(2):577–581. doi: 10.1016/0005-2736(73)90509-9. [DOI] [PubMed] [Google Scholar]
- WEBER M. M., KINSKY S. C. EFFECT OF CHOLESTEROL ON THE SENSITIVITY OF MYCOPLASMA LAIDLAWII TO THE POLYENE ANTIBIOTIC FILIPIN. J Bacteriol. 1965 Feb;89:306–312. doi: 10.1128/jb.89.2.306-312.1965. [DOI] [PMC free article] [PubMed] [Google Scholar]
- Warr J. R., Roper J. A. Resistance to various inhibitors in Aspergillus nidulans. J Gen Microbiol. 1965 Aug;40(2):273–281. doi: 10.1099/00221287-40-2-273. [DOI] [PubMed] [Google Scholar]
- Weissmann G., Sessa G. The action of polyene antibiotics on phospholipid-cholesterol structures. J Biol Chem. 1967 Feb 25;242(4):616–625. [PubMed] [Google Scholar]
- Woods R. A. Nystatin-resistant mutants of yeast: alterations in sterol content. J Bacteriol. 1971 Oct;108(1):69–73. doi: 10.1128/jb.108.1.69-73.1971. [DOI] [PMC free article] [PubMed] [Google Scholar]
- Zygmunt W. A. Intracellular Loss of Potassium in Candida albicans After Exposure to Polyene Antifungal Antibiotics. Appl Microbiol. 1966 Nov;14(6):953–956. doi: 10.1128/am.14.6.953-956.1966. [DOI] [PMC free article] [PubMed] [Google Scholar]
- Zygmunt W. A., Tavormina P. A. Steroid interference with antifungal activity of polyene antibiotics. Appl Microbiol. 1966 Nov;14(6):865–869. doi: 10.1128/am.14.6.865-869.1966. [DOI] [PMC free article] [PubMed] [Google Scholar]